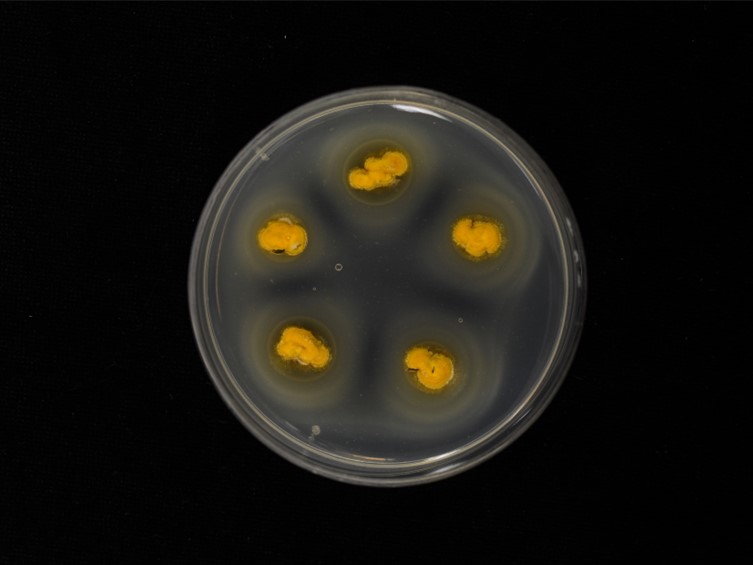

Holotype:
THAILAND, Chanthaburi Province, Khao Yai National Park, 17 Dec. 2014, A. Bootkot, A. Khonsanit, W. Noisripoom, D. Thanakitpipattana, B. Sakolrak, holotype BBH 40785, extype living culture BCC 80047.
Habitat:
Undersides of Durian leaves.
Host:
Scale insects (Hemiptera).
Description:
 Stromata pulvinate, greyish yellow, up to 2-3 mm diam.
Stromata pulvinate, greyish yellow, up to 2-3 mm diam.  Indeterminate synnemata in numbers of 2-30, formed on stromata, up to 800 μm long, 100-120 μm wide.
Indeterminate synnemata in numbers of 2-30, formed on stromata, up to 800 μm long, 100-120 μm wide.  Entire phialides (hirsutella-like) emerging laterally of synnemata, subulate, 12-20, basal part 7-15 × 3-4 μm; attenuated helical neck 5-8 × 1.5 μm.
Entire phialides (hirsutella-like) emerging laterally of synnemata, subulate, 12-20, basal part 7-15 × 3-4 μm; attenuated helical neck 5-8 × 1.5 μm.  Conidia hyaline, fusoid, 10-12 × 3-4 μm, aseptate. Colour change of stromata and synnemata in 3% KOH not observed.
Conidia hyaline, fusoid, 10-12 × 3-4 μm, aseptate. Colour change of stromata and synnemata in 3% KOH not observed.
Culture characteristics:
Colonies on PDA attaining a diam of 0.5 cm diam in 2 wk at 25 °C, aerial mycelium greyish orange forming a compact, somewhat stromatic felt. Conidial masses vivid yellow, covering stromatic colonies at 2 weeks. Phialides (hirsutella-like) formed laterally by hyphae, appearing yellowish because of cell content, entire phialides 12–20 × 3–4 μm, hyaline, helical necks present, up to 10 μm long. Conidia fusoid to cylindrical, hyaline, aseptate, smooth-walled, 8–15 × 3–4 μm.
Colonies on PDA attaining a diam of 0.5 cm diam in 2 wk at 25 °C, aerial mycelium greyish orange forming a compact, somewhat stromatic felt. Conidial masses vivid yellow, covering stromatic colonies at 2 weeks. Phialides (hirsutella-like) formed laterally by hyphae, appearing yellowish because of cell content, entire phialides 12–20 × 3–4 μm, hyaline, helical necks present, up to 10 μm long. Conidia fusoid to cylindrical, hyaline, aseptate, smooth-walled, 8–15 × 3–4 μm.
Reference:
Luangsa-ard JJ, Mongkolsamrit S, Noisripoom W, et al. (2017). Helicocollum, a new clavicipitalean genus pathogenic to scale insects (Hemiptera) in Thailand. Mycological Progress 16: 419–431.
DOI: https://doi.org/10.1007/s11557-017-1283-3Species |
Strain |
Compound |
Pubchem CID |
Biological activity |
Reference |
|---|
|
Strain |
LSU | TEF1 |
|---|---|---|
| BCC 80047 | KT222330 | KT222343 |